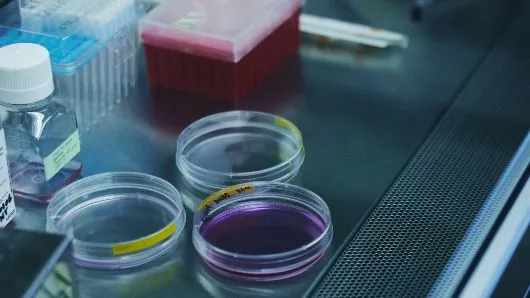

日本を代表する公的研究機関として、産総研が歩んできた25年間の歩みと、
社会課題の解決に向けた技術革新の歴史を、これまでの軌跡とともにご紹介します。













日本を代表する公的研究機関として、産総研が歩んできた25年間の歩みと、
社会課題の解決に向けた技術革新の歴史を、これまでの軌跡とともにご紹介します。